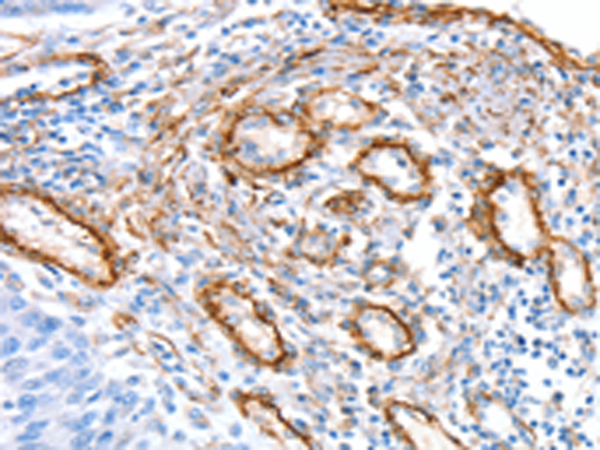

-
分类: 科研抗体货号: P12231别名: NTRKR1; dJ537F10.1应用: IHC反应种属: Human, Mouse
-
分类: 科研抗体货号: P12213别名: hSMAGP应用: IHC反应种属: Human, Mouse, Rat
-
分类: 科研抗体货号: P12219别名: SMA; SMN; SMA1; SMA2; SMA3; SMA4; SMA@; SMNT; BCD541; GEMIN1; TDRD16A; T-BCD541应用: WB反应种属: Human
-
分类: 科研抗体货号: P12230别名:应用: WB,IHC反应种属: Human, Mouse, Rat
-
分类: 科研抗体货号: P12212别名: Met应用: IHC反应种属: Human, Mouse
-
分类: 科研抗体货号: P12218别名: SMC-6; hSMC6; SMC6L1应用: WB,IHC反应种属: Human
-
分类: 科研抗体货号: P12229别名: SNX30; SH3PX3; SH3PXD3C应用: IHC反应种属: Human, Mouse
-
分类: 科研抗体货号: P12210别名: SLIL3; Slit-2应用: WB,IHC反应种属: Human, Mouse, Rat
-
分类: 科研抗体货号: P12247别名:应用: WB,IHC反应种属: Human, Mouse
-
分类: 科研抗体货号: P12227别名: RUNDC2A; A-388D4.1应用: IHC反应种属: Human, Mouse

鄂公网安备42018502007531号
鄂公网安备42018502007531号

